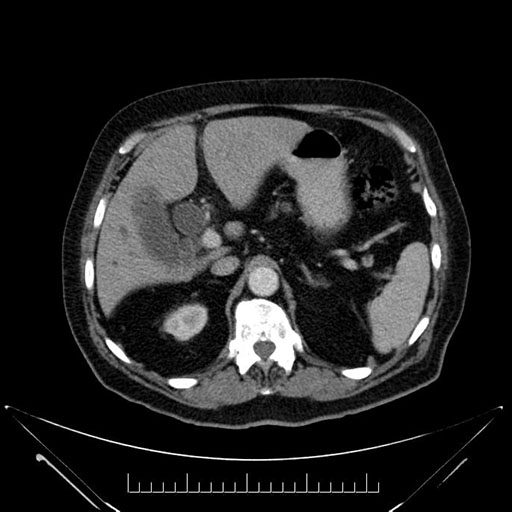
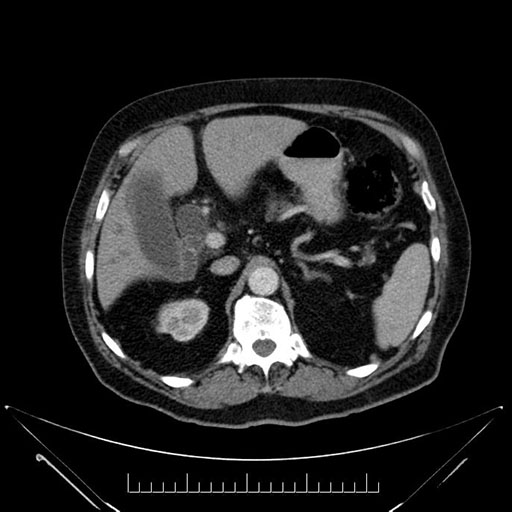
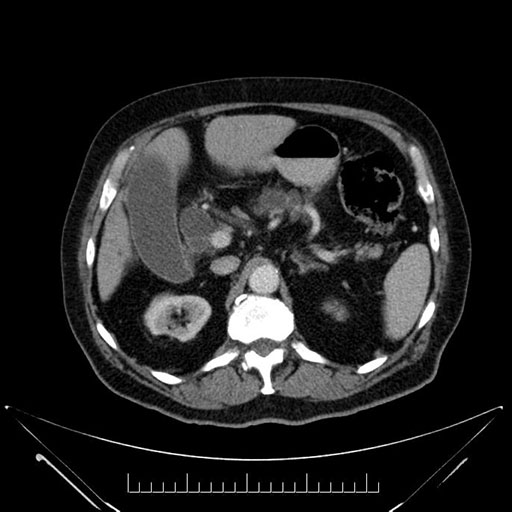
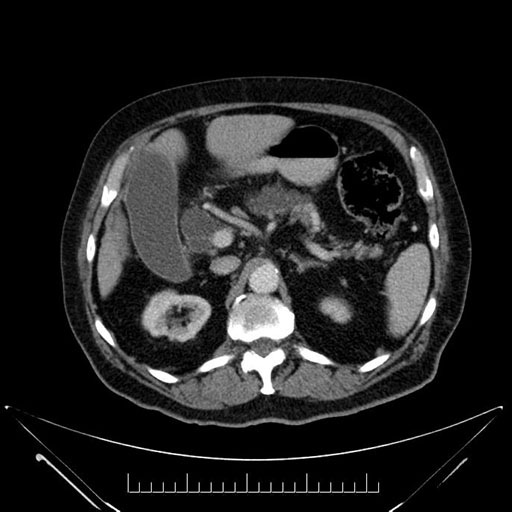
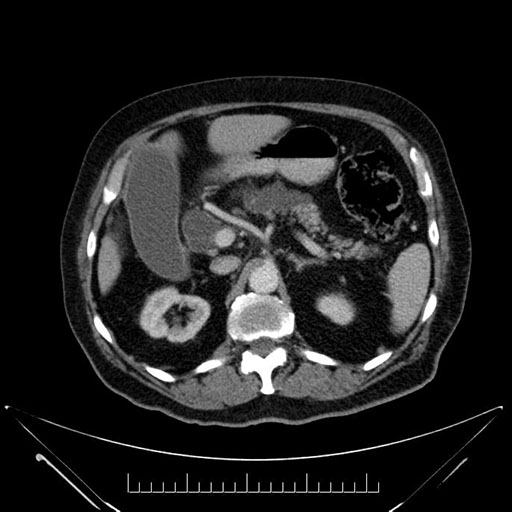
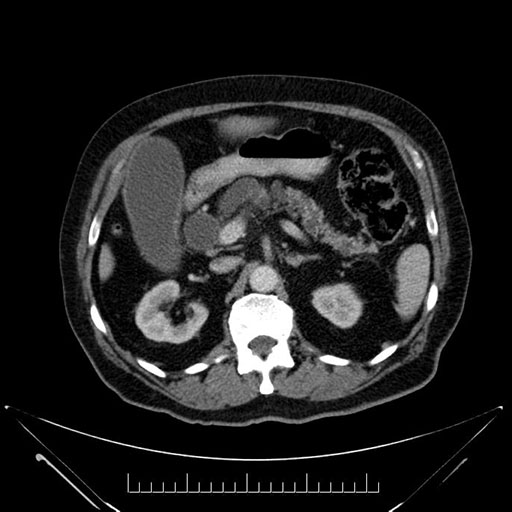
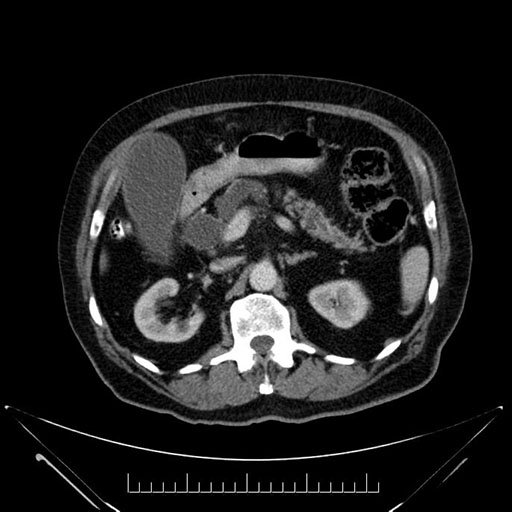
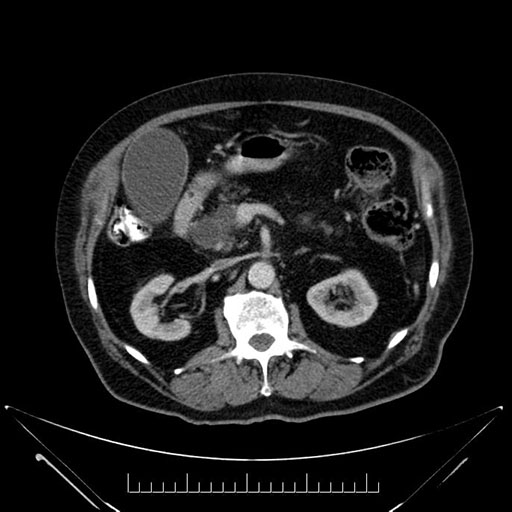
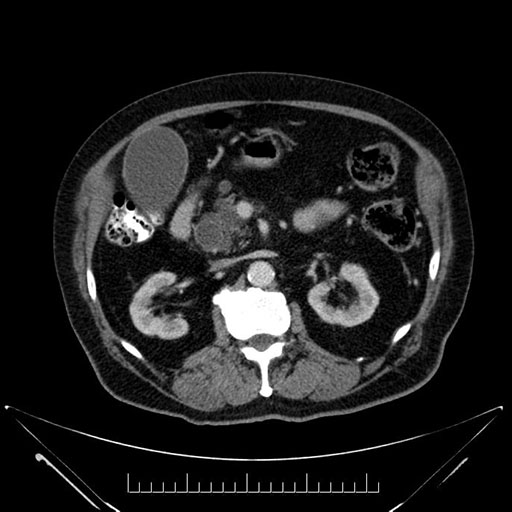
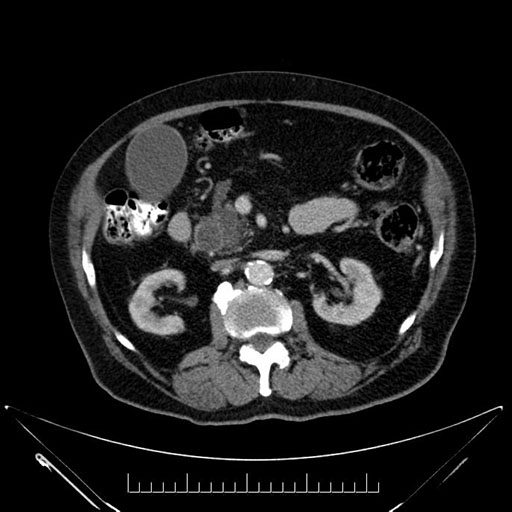
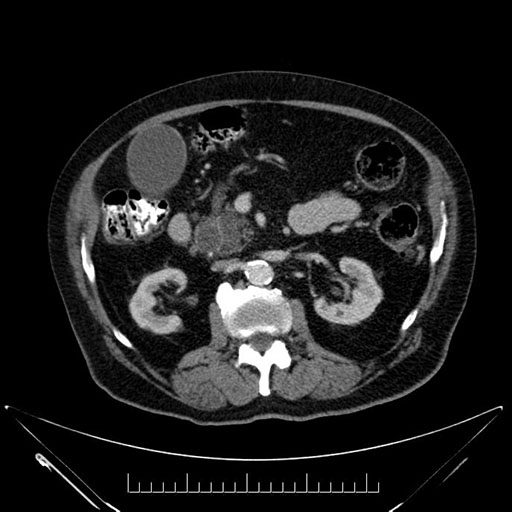
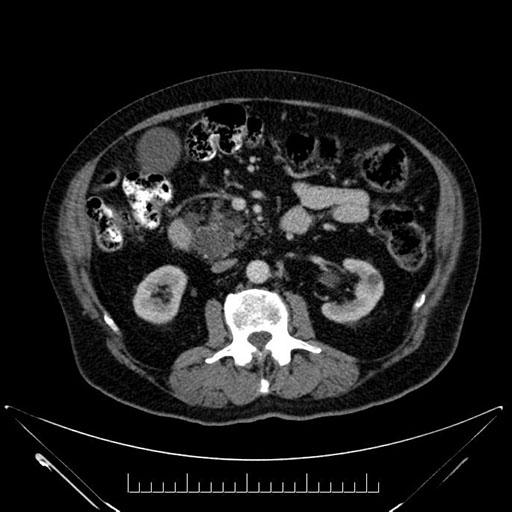
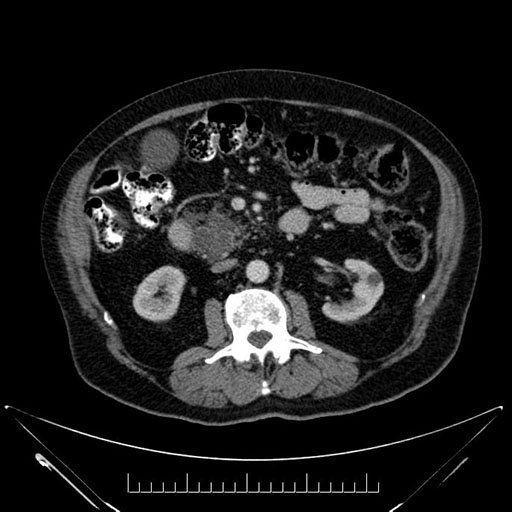
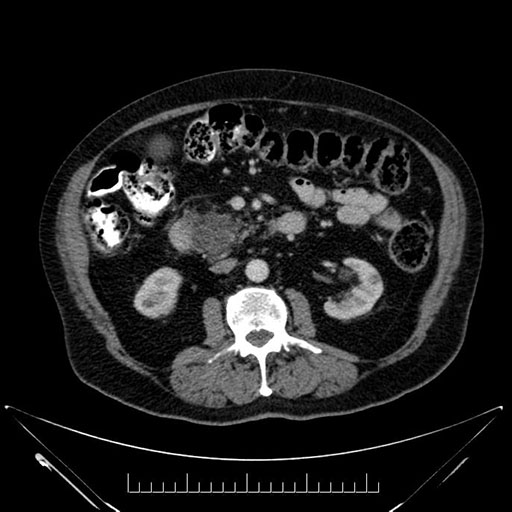
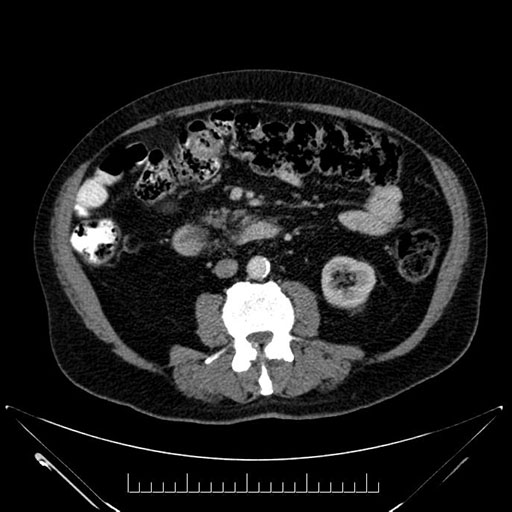
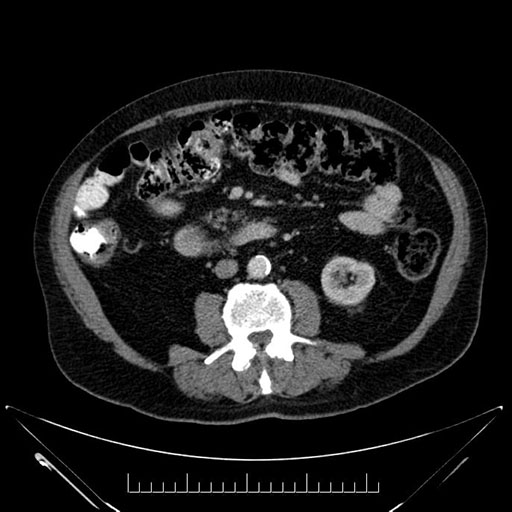
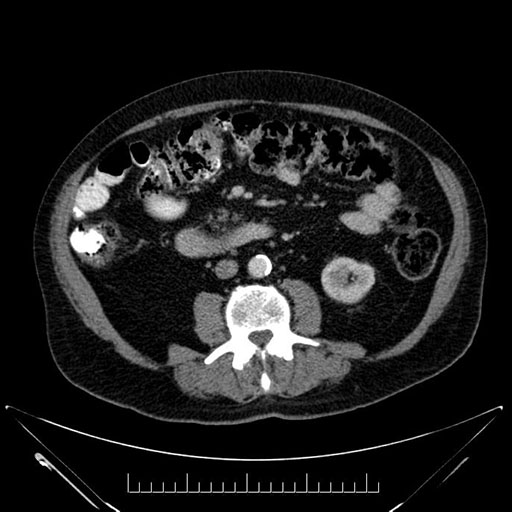
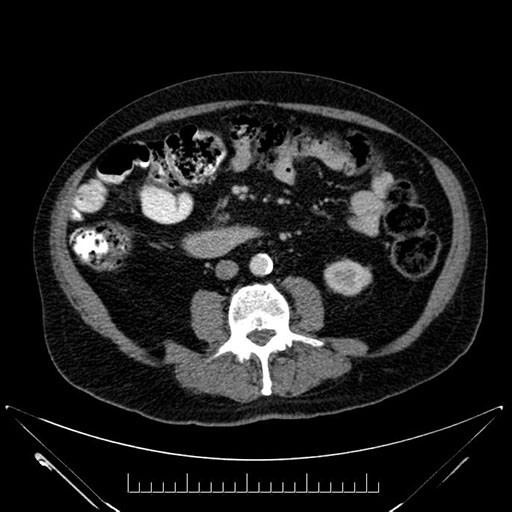
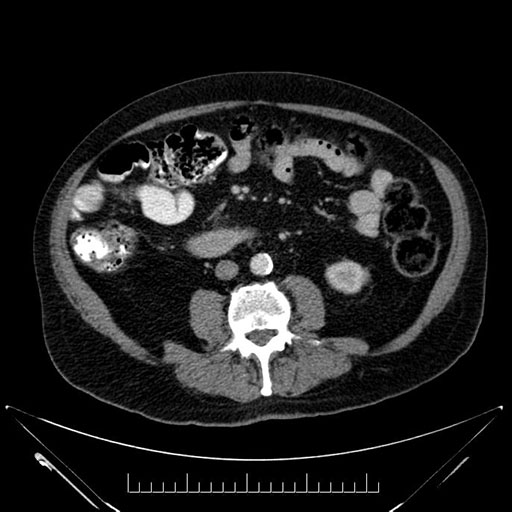
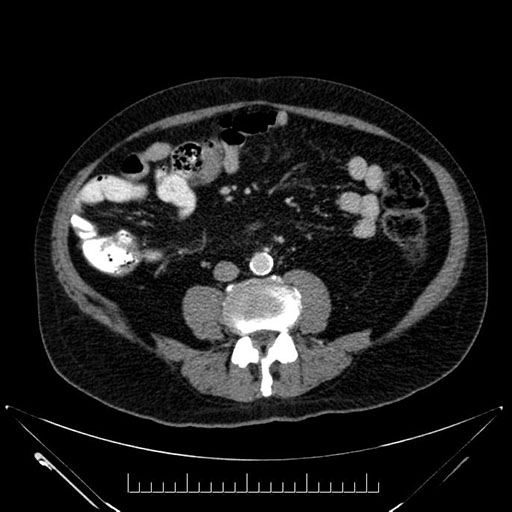
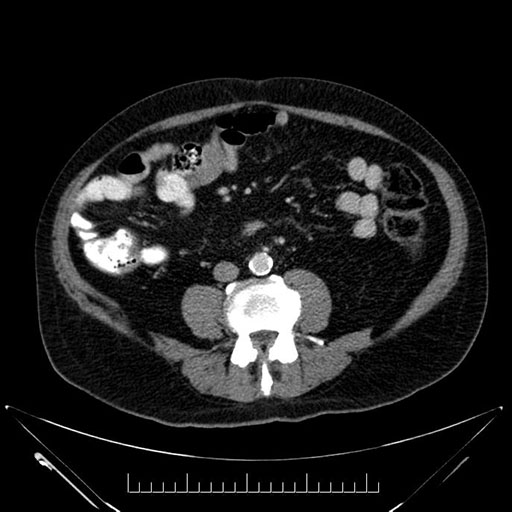
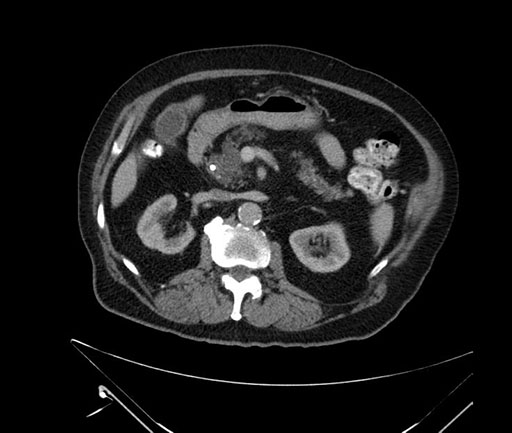
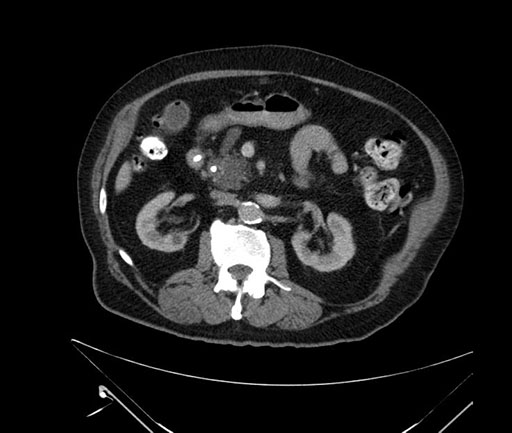
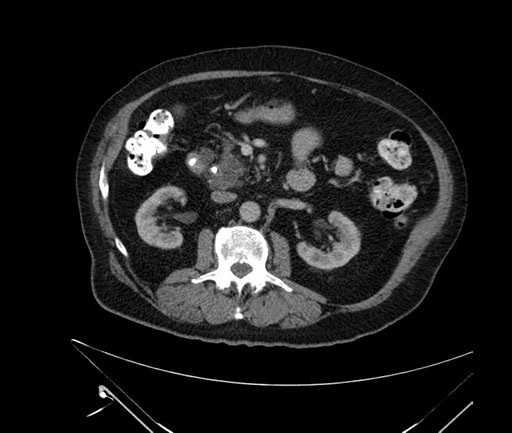
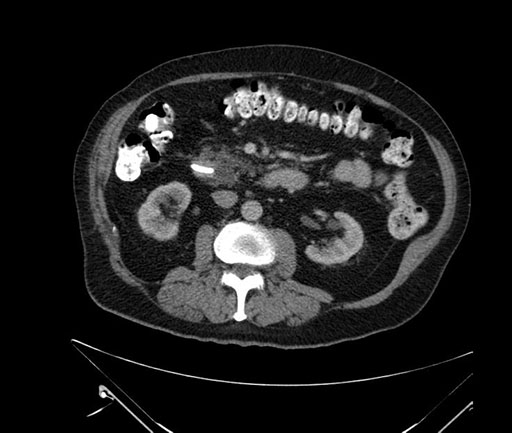
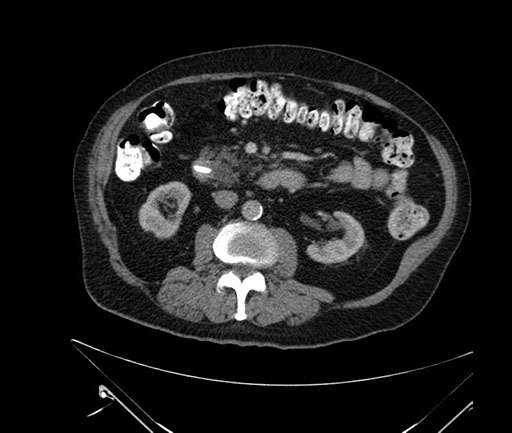
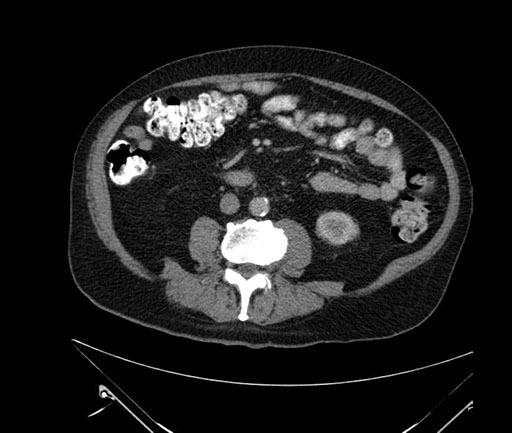
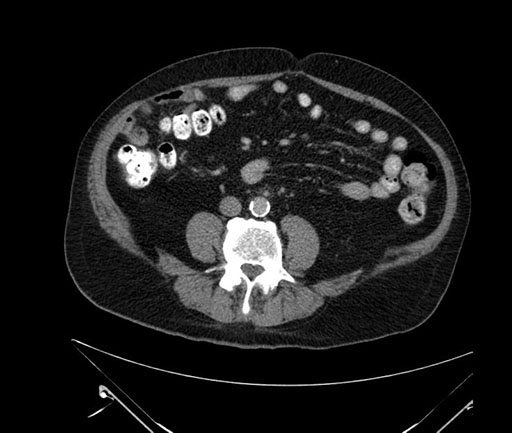

International Hepato-Pancreato-Biliary Association
Whipple (pancreaticoduodenectomy) [case 7]
Imaging Analysis
Look through the patient's CT scan to identify any areas of concern for the necessary procedure.
Imaging analysis
Based on your CT findings, which issue(s) would give reason for "planned slowing down moment(s)" in this case?
Considering a standard Whipple procedure, what step(s) of the operation would you do differently in this case?
Acknowledgements
Thank you to the HPB Surgeons who contribute their time and expertise. This content is made possible through educational grants from:
Case 28

Views and opinions expressed in all videos and module content are those of the individual surgeon and solely intended for surgical education purposes. We do not endorse any product, treatment or therapy.
Corporate Partners
If you are interested in becoming a Corporate Partner of the IHBPA please contact industry@ihpba.org
Find out more
 Go to myHPB
Go to myHPB